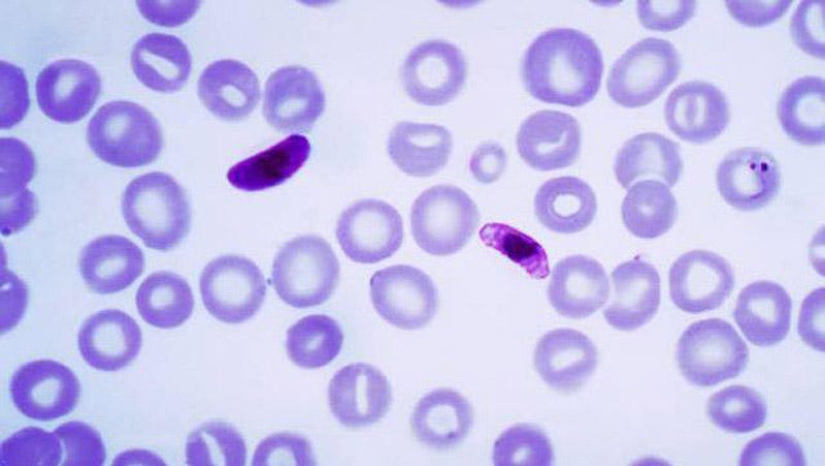
Los 25 parásitos más inusuales y peligrosos

Los 25 parásitos más inusuales y peligrosos
Categorias: Animales | Salud y Medicina
Por Pictolic https://www.pictolic.com/es/article/los-25-parsitos-ms-inusuales-y-peligrosos.htmlEl parasitismo se encuentra en todas partes en la naturaleza. Hay animales parásitos, insectos parásitos, gusanos parásitos, plantas parásitas y muchos otros. Hay tantos que incluso algunos parásitos tienen sus propios parásitos, y estos “subordinados” pueden ser especialmente peligrosos y sanguinarios.
Un ejemplo sorprendente de esta “jerarquía de la oscuridad” es el plasmodio de la malaria. Este organismo unicelular parasita al mosquito de la malaria, que a su vez es un parásito temporal de los animales de sangre caliente y de los seres humanos. Cada año, el parásito de la malaria causa casi un tercio de billón de nuevas víctimas y provoca la muerte de más de un millón de personas.
¡Atención! Algunas fotos no son para los débiles de corazón.

El parásito más “valiente” es, quizá, el que se puede llamar sanguijuela medicinal. Ella no se limita a beber la sangre de su amo, sino que lo hace con un "tacto" especial. En primer lugar, intenta que el proceso sea completamente indoloro y, en segundo lugar, durante su “almuerzo” incluso ayuda al dueño a librarse de algunas enfermedades.
Todos los parásitos, sin excepción, llevan un estilo de vida gorroneador, minando gradualmente los recursos de la misma “perra” sobre la que están sentados. Sin embargo, a pesar de que no necesitan buscar comida (al fin y al cabo, viven en su interior), su existencia no puede considerarse fácil ni cómoda. El cuerpo del anfitrión intenta constantemente destruir a los huéspedes no invitados. Para sobrevivir en condiciones tan hostiles, los parásitos tienen que recurrir a los trucos más increíbles. Te invitamos a echar un vistazo a los 25 representantes más inusuales de este mundo.

Este percebe es un parásito de los cangrejos. Literalmente crece a través de todo el cuerpo del huésped, succionando sus jugos nutricionales. El cangrejo se debilita gradualmente e incluso pierde la capacidad de regenerarse. Cuando llega el momento de que el parásito se reproduzca, inyecta sustancias químicas especiales en la sangre del cangrejo, lo que hace que las hembras comiencen a cuidar los huevos del parásito como si fueran suyos. El cangrejo macho parasitado se niega a aparearse y, en lugar de ello, bajo la influencia de una droga química, cuida los huevos del parásito de la misma manera que la hembra.

Ophiocordyceps unilateralis es un hongo parásito que convierte a las hormigas en auténticos zombis dignos de un guión de película de terror, y lo hace con una espeluznante sofisticación. Vive en los bosques tropicales e infecta a las hormigas carpinteras penetrando en sus cuerpos a través de esporas. Una vez dentro, el hongo toma el control del comportamiento del insecto: la hormiga abandona sus actividades habituales, trepa a la planta más cercana y se aferra fuertemente a una hoja con sus mandíbulas: este es su último acto.
El Cordyceps se alimenta de su huésped desde el interior, absorbiendo gradualmente todos sus recursos hasta que un tallo espeluznante con una “tapa” similar a un hongo brota de la cabeza de la hormiga. Este tallo libera nuevas esporas para encontrar a sus próximas víctimas. Los científicos lo han bautizado como el «hongo zombi» por su capacidad de controlar por completo el comportamiento del insecto, dirigiéndolo a la altura ideal para esparcir sus esporas. No es un simple parásito, sino un auténtico titiritero de la selva, que demuestra que la naturaleza a veces da más miedo que cualquier película de terror.

Una persona puede infectarse con estos gusanos si come pescado, camarones, calamares o pulpos mal cocinados que estén infectados con los parásitos. El primer caso de infección por anisakiasis se registró oficialmente en 1955 en Holanda y la fuente de infección fue el arenque ligeramente salado.
Si al cortar el pescado notas “formaciones en espiral” en su tejido muscular, huevas o lecha, tienes dos opciones: o bien tirar el manjar sin piedad, o bien congelar el pescado a una temperatura de -20 grados y mantenerlo en este estado durante al menos dos semanas. Con este tratamiento morirán los gusanos y sus larvas microscópicas. Después de esto, el pescado se puede comer, aunque es poco probable que el hecho de que esté infectado aumente el apetito.

Wolbachia es una bacteria manipuladora que vive dentro de las células de los insectos y controla sutilmente su destino. Este pequeño "intrigador" vive en mosquitos, moscas, mariposas e incluso arañas, ¡infectando aproximadamente el 60% de todas las especies de insectos del planeta! Ella no es sólo un parásito, sino una verdadera maestra del control biológico. Wolbachia puede esterilizar a los machos, convertirlos en hembras o incluso cambiar los métodos reproductivos del huésped para que sus propios genes puedan transmitirse.
Por ejemplo, los mosquitos Aedes aegypti infectados, con la ayuda de la bacteria Wolbachia, se convierten en malos portadores de enfermedades como el dengue o el virus del Zika. Es un truco inteligente que utilizan los científicos para combatir las infecciones. La bacteria se transmite a través de los huevos de insectos, como una herencia secreta, y es completamente segura para los humanos. Sin embargo, en el mundo de los escarabajos y los mosquitos, ¡Wolbachia es la verdadera reina de la intriga detrás de escena, moviendo los hilos de la vida y la reproducción!

La pulga de arena es un parásito extremadamente peligroso que afecta a animales domésticos, roedores, monos y humanos. Su amplia distribución plantea un grave problema para países como Nigeria, Togo e incluso Brasil. En las zonas desfavorecidas, la proporción de personas afectadas por este parásito puede alcanzar el 70%. Es extraño, pero las pulgas de arena atacan con mayor frecuencia a los hombres.
Cuando se infecta, la pulga hembra microscópica excava en la piel de las piernas o debajo de las uñas. En sólo 5-6 días, su vientre, lleno de huevos, se hincha hasta el tamaño de un guisante, provocando un dolor intenso al dueño. Cuando los huevos maduran, la hembra los “dispara” al ambiente, tras lo cual intenta salir de la herida. Sin embargo, la mayoría de las veces muere directamente en el cuerpo humano, lo que puede provocar complicaciones graves.

La avispa Hymenoepimecis argyraphaga es un verdadero genio parásito de los bosques tropicales de Costa Rica, que convierte la vida de las arañas en un escenario de película de terror. Esta avispa de la familia Ichneumonidae caza arañas de la especie Plesiometa argyra, y sus métodos sorprenden por su cruel ingenio.
La avispa hembra paraliza temporalmente a la araña con una picadura y pone un huevo directamente en su abdomen. Cuando la larva eclosiona, comienza a alimentarse de la sangre de la araña, como un pequeño vampiro, mientras la araña continúa tejiendo telarañas y llevando una vida "normal". Pero entonces llega el clímax: antes de convertirse en pupa, la larva inyecta una sustancia química especial en la araña. Esto hace que la araña cree una extraña red reforzada, no para atrapar presas, sino como plataforma perfecta para el futuro capullo de la avispa.
Después de completar su trabajo, la araña se congela y la larva la mata, succiona los recursos vitales restantes y construye su capullo sobre esta espeluznante estructura. Hymenoepimecis argyraphaga es un auténtico maestro de la zombificación, demostrando claramente que la naturaleza puede ser a la vez aterradora e increíblemente brillante.

De hecho, este pequeño pez translúcido parasita las branquias de otros peces que viven en los ríos del Amazonas. Pero cuando busca una presa, el candirú se guía por el olor del amoniaco, que está contenido en el agua que ha pasado por sus branquias. Esto es lo que lo hace extremadamente peligroso para los humanos. Si una persona está en el agua, entonces, al percibir una señal química, el candirú penetra instantáneamente en el ano o la uretra de la persona, llegando a veces incluso a la vejiga. Una vez dentro del cuerpo, el candirú muere inevitablemente, pero la herida que logra infligir es simplemente terrible, y sólo un buen cirujano puede extraer su cuerpo muerto, cubierto de tenaces espinas.

Trichomonas es un microorganismo unicelular flagelado. Algunos tipos de tricomonas son completamente inofensivos, pero también los hay que son verdaderamente asesinos. En las aves, estos parásitos pueden causar una inflamación grave en la boca y la garganta, lo que hace que el ave no pueda tragar y finalmente muera.
Otro tipo de tricomonas (tricomonas vaginales) parasita los órganos genitourinarios humanos y causa una grave enfermedad llamada tricomoniasis, que hoy en día es la enfermedad más común del tracto genitourinario en la Tierra. Las estadísticas médicas dicen que casi uno de cada diez habitantes del planeta padece esta enfermedad.

Se trata de un grupo completo de protozoos que causan enfermedades graves conocidas como leishmaniasis. Por ejemplo, la leishmaniasis cutánea, que provoca úlceras dolorosas, es causada por parásitos que primero viven en mosquitos o moscas y luego pasan a los animales de sangre caliente, incluidos los humanos.
Al principio, estos parásitos se multiplican tan activamente en el tracto digestivo del insecto chupador de sangre que bloquean completamente su trabajo. Cuando un insecto pica a una persona, primero regurgita una masa de parásitos en la herida y sólo entonces comienza a beber sangre. La leishmaniasis está muy extendida en los países tropicales y cada año se notifican aproximadamente dos millones de casos nuevos de infección en todo el mundo.

La cochinilla comelenguas (*Cymothoa exigua*) es un parásito marino que parece sacado de una pesadilla, pero que realmente existe en las profundidades del océano. Este pequeño crustáceo de la familia *Cymothoidae* vive en la boca de los peces, especialmente de los pargos, y convierte sus vidas en un auténtico horror.
Penetrando a través de las branquias, la hembra de la cochinilla llega a la boca del pez, se aferra a su lengua y comienza a chuparle sangre hasta atrofiarlo y morir completamente. Pero su trabajo no termina ahí: en lugar de la lengua perdida, la cochinilla toma su lugar, adhiriéndose al tocón y convirtiéndose en una especie de “prótesis viviente”. El pez continúa viviendo e incluso alimentándose con este “sustituto”, y el parásito obtiene su parte de alimento.
*Cymothoa exigua* es el único parásito conocido que puede reemplazar completamente el órgano del huésped. No se trata de un simple devorador, sino de un auténtico “ingeniero” marino, que demuestra claramente que en la naturaleza todo es posible, ¡incluso lo más increíble y salvaje!

El tripanosoma es un parásito diminuto pero extremadamente peligroso que convierte la vida de sus víctimas en una pesadilla. Las enfermedades que provoca, como la enfermedad del sueño en los humanos y la nagana en los animales, lo convierten en uno de los enemigos más insidiosos de las regiones tropicales. Los tripanosomas son transportados por insectos chupadores de sangre, como las moscas tsé-tsé, que introducen este “invasor” microscópico directamente en la sangre.
Una vez en el cuerpo, los tripanosomas comienzan su viaje a través de los vasos sanguíneos y el sistema linfático, alterando el funcionamiento de los órganos internos. En los humanos, causa fiebre, debilidad, confusión y, si no se trata, puede provocar letargo o incluso la muerte. Especialmente temida es la especie Trypanosoma brucei, considerada la principal culpable de la enfermedad del sueño.
Este parásito es un auténtico maestro del disfraz: cambia constantemente sus proteínas, engañando al sistema inmunológico. Esto hace que sea extremadamente difícil combatirlo. El tripanosoma es un ejemplo sorprendente de cómo un pequeño patógeno puede causar enormes problemas para la salud y la vida de millones de personas y animales.

Los microorganismos más simples que causan una enfermedad grave: la toxoplasmosis. Los principales huéspedes del parásito son los gatos; los humanos y otros animales de sangre caliente actúan como huéspedes intermediarios. La toxoplasmosis a menudo puede ser muy leve y disfrazarse de un resfriado común. Pero con una disminución de la inmunidad, la enfermedad puede causar locura, convulsiones, parálisis y otros daños al sistema nervioso. La toxoplasmosis es especialmente peligrosa para las mujeres embarazadas, ya que provoca la muerte del niño incluso antes del nacimiento.

Las hembras de esta mosca, que vive en América, adhieren invisiblemente sus huevos a los cuerpos de animales de sangre caliente. Las larvas que nacen de los huevos excavan bajo la piel y abren agujeros enteros en el cuerpo de la víctima. Especialmente peligrosos son aquellos tipos de moscas que ponen huevos en los ojos y la nariz. En este caso, las larvas, devorando la carne del huésped, pueden causar ceguera e incluso llegar al cerebro. Se conocen casos en los que los médicos extrajeron más de 150 larvas de la nasofaringe de una persona infectada con este parásito.

La Gordiacea es un parásito que parece sacado de una película de terror: un gusano largo y delgado como un cabello que puede crecer hasta un metro de largo. Estos representantes de la familia de los nematomorfos viven en cuerpos de agua y sus larvas son verdaderas maestras de la manipulación. Entran en el cuerpo de insectos como saltamontes o escarabajos y los convierten en obedientes marionetas.
El insecto infectado de repente empieza a comportarse de manera extraña: por ejemplo, decide “nadar” en el agua, aunque normalmente lo evita. Es allí donde el gusano abandona el cuerpo del huésped, abandonándolo a su destino. Incluso había leyendas de que la gente tenía miedo de beber agua de los ríos, por temor a tragarse un “cabello vivo” que supuestamente comenzaría a crecer en su interior. De hecho, es inofensivo para los humanos, pero ver un gusano de un metro de largo salir de un escarabajo no es un espectáculo para los débiles de corazón. Hairy es un auténtico titiritero de la naturaleza, y sus "performances" ponen los pelos de punta incluso a los más perseverantes.

Hay casi 10 especies diferentes de filarias que parasitan a los humanos. Estos gusanos extremadamente delgados (su diámetro no supera los 0,3 mm) pueden crecer hasta casi medio metro de longitud. La filariasis se transmite por insectos chupadores de sangre. En el cuerpo humano, los gusanos pueden vivir casi en cualquier lugar. Cuando bloquean el sistema linfático se desarrolla elefantiasis y si se acumulan en los ojos la persona puede quedar ciega.

El gusano redondo delgado Loa loa pertenece a las filarias y está muy extendido en África occidental y central. El parásito se transmite por tábanos y otros insectos chupadores de sangre. Los gusanos adultos viven debajo de la piel. Las hembras dan a luz inmediatamente larvas vivas, que se acumulan en los pulmones y los vasos sanguíneos periféricos, provocando diversos tumores y reacciones inflamatorias. Los gusanos migran constantemente por todo el cuerpo y, si entran en los ojos, pueden provocar ceguera.

Clostridium perfringens es un auténtico matón bacteriano al que le encanta arruinar los picnics con barbacoa y provocar un caos total en los intestinos. Este microbio vive en el suelo, en el polvo y, lo más importante, en la carne mal cocida o en una sopa que ha estado demasiado tiempo en la mesa. Una vez en el cuerpo, los clostridios comienzan a liberar toxinas, convirtiendo el estómago en un escenario de “protestas violentas”: calambres, diarrea y una sensación como si un volcán hubiera despertado en tu interior.
La han apodado la "Reina de la intoxicación alimentaria", pero sus "talentos" no terminan ahí. En casos raros, puede causar gangrena gaseosa, cuando los tejidos literalmente comienzan a descomponerse debido a sus “trucos” venenosos. A esta "bestia" anaeróbica le encantan los lugares sin oxígeno, como heridas profundas o alimentos enlatados olvidados hace mucho tiempo. Así que, vigila tus alimentos, guárdalos en el refrigerador y lávate las manos: ¡el Clostridium siempre está despierto y listo para organizar su carnaval tóxico!

El Schistosoma es un gusano plano parásito que ama las aventuras acuáticas y la sangre humana, convirtiendo un baño inofensivo en una verdadera pesadilla. Estas insidiosas criaturas del género Schistosoma, presentes en cuerpos de agua dulce de África, Asia y Sudamérica, ingresan al cuerpo a través de la piel cuando disfrutas de un baño en un río o lago.
Sus larvas, como arpones en miniatura, se clavan en el cuerpo y luego comienzan su viaje a través de los vasos sanguíneos, construyendo allí su “acogedor hogar”. Lo peor ocurre cuando ponen huevos: el cuerpo empieza a rebelarse, se produce inflamación y, a veces, incluso sangre en la orina o las heces: ¡"hola" del esquistosoma! Especies como Schistosoma mansoni pueden provocar que el hígado y los intestinos queden completamente agotados. Los lugareños llaman a esta enfermedad "fiebre del caracol" porque los caracoles sirven como huéspedes intermediarios del parásito. Así que, si estás planeando sumergirte en un río tropical, piénsalo dos veces: ¡tal vez este vampiro acuático ya esté acechando allí!

La ceguera de los ríos, u oncocercosis, no es el título de una novela de suspense, sino un “regalo” insidioso de un parásito que ama los ríos y la piel humana. El agente causal de la enfermedad es el gusano Onchocerca volvulus, y se transmite por el mosquito negro Simulium, cuyas picaduras literalmente te hacen aullar de irritación. Estos mosquitos viven cerca de ríos de corriente rápida en África, América Latina y Oriente Medio, convirtiendo los cuerpos de agua en verdaderos focos de infección.
Una vez bajo la piel, las larvas del gusano comienzan a crecer, a multiplicarse y a causar allí un caos total, liberando millones de crías microscópicas. ¿Resultado? Picazón intensa, piel que parece cáscara de naranja y, en el peor de los casos, ceguera cuando los parásitos llegan a los ojos y arruinan tu vida por completo. No en vano la enfermedad se llama “ceguera de los ríos”: afecta especialmente a los pescadores y agricultores que viven cerca del agua y puede privarlos de su tesoro principal: la vista. Afortunadamente, hoy en día se combate con ayuda de medicamentos y mosquiteros, ¡pero el mosquito aún no se da por vencido!

El meningococo es una bacteria invisible a la que le encanta jugar al escondite con nuestro sistema inmunológico y al mismo tiempo crear verdaderos suspense en el cuerpo. En los círculos científicos se le llama Neisseria meningitidis. Vive silenciosamente en la nasofaringe de muchas personas, sin revelar su presencia. Sin embargo, una vez que penetra en la sangre o en las meninges, comienza el verdadero caos: fiebre, una erupción que parece un cielo estrellado y una meningitis relámpago, de la que la cabeza literalmente se “parte”.
Este microbio insidioso se transmite a través de la saliva: basta con estornudar, besar o beber de la taza de otra persona para encontrarse en la zona de riesgo. Le gustan especialmente los jóvenes y los niños, y convierte un resfriado inofensivo en el escenario de una novela policíaca médica. Aunque existen vacunas contra el meningococo, éste sigue siendo un maestro del camuflaje. ¡Así que es mejor no darle ni una sola oportunidad de salir al frente!

La mosca tsé-tsé es una auténtica estrella del mundo de los insectos, sólo que con una afición sangrienta y una mala reputación. Originaria de África tropical, esta pequeña mosca hematófaga (de 9 a 14 mm) del género Glossina no sólo pica molestamente, sino que también es portadora de parásitos mortales como los tripanosomas. Es a través de sus picaduras que los patógenos de la enfermedad del sueño en humanos o de la nagana en el ganado ingresan al cuerpo de una persona o animal.
Imagina que estás disfrutando de unas relajantes vacaciones en la sabana, y este cazador alado con una probóscide afilada decide que tú eres su próxima comida. Una sola picadura y fiebre, comienza la debilidad y, si no se trata, un sueño prolongado del que es posible que nunca despiertes. Entre las 23 especies de mosca tsé-tsé, las más notorias son los "amos", como la Glossina morsitans, que aterrorizan a las aldeas africanas, causando enormes daños al ganado y a la salud humana. Curiosamente, pliega sus alas sobre su espalda como si fuera un sobre ordenado, lo que la distingue de las moscas comunes. ¡Elegante, pero extremadamente peligroso!

El gusano es común en África, India y la Península Arábiga. Las larvas microscópicas viven en agua dulce y, cuando llega el momento, atacan a los animales y a las personas, penetrando bajo la piel. Los gusanos adultos pueden alcanzar 2 mm de espesor y 1 m de longitud. Después del apareamiento, los gusanos machos mueren y las hembras se trasladan a la capa subcutánea, perforan la piel y cuando una persona termina en el agua, liberan las larvas a través del agujero que hicieron.
Plasmodium es un astuto parásito microscópico que adora viajar a través de los vasos sanguíneos y causar un verdadero caos en los cuerpos de sus víctimas. Este pequeño "vampiro" del género Plasmodium es conocido como el principal culpable de la malaria. Es él quien hace que la gente tiemble de fiebre y sueñe con limonada fresca. El Plasmodium se transmite a través de las picaduras de mosquitos, que ni siquiera sospechan que están sirviendo como mensajeros de este huésped no invitado.
Una vez en la sangre, el plasmodio captura rápidamente los glóbulos rojos, se multiplica en ellos a una velocidad increíble y convierte el cuerpo del huésped en su propio "hotel de cinco estrellas". Los científicos cuentan más de 100 especies de este parásito. Sin embargo, los más famosos de ellos, por ejemplo, Plasmodium falciparum, son considerados verdaderos profesionales en su campo. Pueden convertir un día normal en una pesadilla tropical.

Esta ameba vive en cuerpos de agua dulce cuya temperatura del agua es de 25 a 30 grados. Una persona se infecta mientras nada. La infección con estos parásitos puede causar meningitis mortal. A veces, incluso las piscinas con agua poco clorada se convierten en fuentes de infección. Estos casos son raros, pero cada vez provocan un verdadero pánico, ya que las víctimas son los visitantes de piscinas, balnearios, fuentes termales y baños.

Leucochloridium paradoxum es un gusano plano parásito que se alimenta de caracoles y pájaros. Los caracoles actúan como huéspedes intermediarios. A medida que la larva se desarrolla, penetra en el cuerpo del caracol y cuando una de sus excrecencias (llamada esporocisto) alcanza un tentáculo, se transforma. Como resultado, el tentáculo comienza a parecerse a una oruga verde, que a los pájaros les encanta picotear. Para camuflarse aún más, la larva mueve constantemente este crecimiento, imitando los movimientos de una oruga real. Todo esto es necesario para atraer al pájaro y obligarlo a comerse la “oruga”.
En el cuerpo del ave, el gusano alcanza la madurez, se reproduce y pone huevos. Estos huevos caen al suelo junto con los excrementos del pájaro y el ciclo comienza de nuevo. La “paradoja” particular de este parásito es que el caracol, al perder un tentáculo, normalmente no muere. En lugar de eso, le crece uno nuevo. Luego, la larva que queda en el cuerpo del caracol forma otro esporocisto y vuelve a atraer a los pájaros.
Artículos Recientes

Ya es hora de admitir que toda esta idea hipster ha ido demasiado lejos. El concepto se ha vuelto tan popular que incluso los ...

Hay una percepción de que las personas sólo utilizan el 10% de su cerebro potencial. Pero los héroes de nuestra revisión, al ...

Año Nuevo es una época para sorprender y deleitar a los seres queridos, no solo con regalos, sino también con una presentación ...